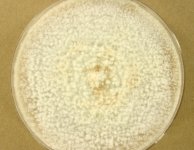
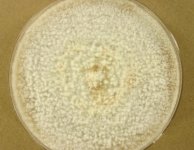

<< back to search
IMAGES:







Search Details
add to cart
| UAMH Number: | 11654 |
|---|---|
| Species Name: | Fomes fomentarius |
| Type: | |
| Synonyms: | Agaricus fomentarius / Boletus fomentarius / Boletus ungulatus / Elfvingia fomentaria / Elfvingiella fomentaria / Fomes albescens / Fomes excavatus / Fomes fomentarius subsp. fomentarius / Fomes griseus / Fomes introstuppeus / Fomes mirus / Fomes nigrescens / Fomes niveus / Fomes subzonatus / Ochroporus fomentarius / Placodes fomentarius / Polyporus fomentarius / Polyporus fomentarius var. excavatus / Polyporus fomentarius var. lineatus / Polyporus introstuppeus / Polyporus mirus / Polyporus populinus / Pyropolyporus fomentarius / Scindalma fomentarium / Scindalma introstuppeum / Scindalma mirum / Ungularia albescens / Ungularia nivea / Ungularia populina / Ungularia subzonata / Ungulina fomentaria |
| Taxonomy: | FUNGI Basidiomycota, Agaricomycetes, Polyporales, Polyporaceae |
| Strain History: | Tudor, D (DT418810) -> UAMH |
| Substrate: | on dead birch | Location: | CANADA Ontario, Toronto, High Park (GEO: 43.647,-79.464) |
| Isolator: | D. Tudor |
| Isolation Date: | 2010-08-01 |
| Date Received: | 2012-07-26 |
| Characters: | BIODETERIOGEN/ BIODEGRADATION influence of pH on pigment formation by lignicolous fungi - Tudor D, Robinson SC, Cooper PA, Int Biodeter Biodegrad 80:22-28, 2013 // CULTURE CONDITIONS no clamps - // PIGMENT brown - fide UAMH 2012 (Click for publications citing UAMH 11654) |
| Compounds: | |
| Cross Reference: | TRTC 167760 |
| Collections: | Living Strains; Dried Herbarium Material |
| Pathogenic Potential: | Human: no | Animal: no | Plant: no |
| Biosafety Risk Group: | RG1 (check the PHAC ePATHogen Risk Group Database for updates) |
| Regulatory Requirements: | No restrictions for Canadian requesters. International requesters must provide all legally required importation documentation prior to shipment. Plant pathogenicity status may be verified by using the USDA Agricultural Research Service (ARS) Fungal Database |
| MycoBank ID: | 194860 |
| Sequences: | >UAMH11654_JX843719 CATTAACGAGTTTTGACATGGGTTGTAGCTGGCCTTCCGAGGCATGTGCACGCCCTGCTCATCCACTCTACACCTGTGCACTTACTGTGGTTTCAGGTGCGTCGCCTCGCGGCGGCGTCACTCGGCCCACGTTTTCTTTACAAACTATTGAAGTAACAGAATGTTTATTGATGTAACGCATCTATAATACAACTTTCAGCAACGGATCTCTTGGCTCTCGCATCGATGAAGAACGCAGCGAAATGCGATAAGTAATGTGAATTGCAGAATTCAGTGAATCATCGAATCTTTGAACGCACCTTGCGCTCCTTGGTATTCCGAGGAGCATGCCTGTTTGAGTGTCATGAAATTCTCAACCTACAAACCTTTGCGGGTTTGTAGCGTTGGATGTTGGAGGCTTTTTGCTGGCCCAGTCAGCTCCTCTTAAATGCATTAGCTTGGTTCCTTGTGGATCGGCTGTCGGTGTGATAATGTCTACGCCGCGACCGTGAAGCGTTTGGAGAGCTTCTAATGGTCTCGTCAGAGACAGCTTTTATGAACTCTGACCT |
IMAGES: